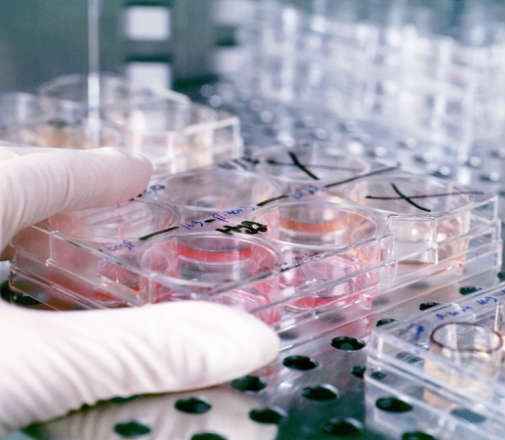
alsharq

أكدت وزارة الداخلية أهمية الوقاية من حرائق المركبات مع ارتفاع درجات الحرارة خلال فصل الصيف، باتباع بعض الإرشادات الهامة، مشددة على أن الوعي...
رئيس مجلس الإدارة : د. خالد بن ثاني آل ثاني

رئيس التحرير: جابر سالم الحرمي

مساحة إعلانية
مساحة إعلانية
صحة وأسرة
331
تكنولوجيا "مكوكية للمخ" تفتح باب الأمل لعلاج الزهايمر
توصلت شركة روش السويسرية للمستحضرات الطبية لطريقة ناجعة تمكن أدوية تستخدم الأجسام المضادة من الوصول إلى المخ واختراقه وهو ما يفتح باب الأمل في التوصل إلى علاجات فعالة لأمراض منها الزهايمر.
وأجريت التجارب على تكنولوجيا مكوك المخ المستحدثة على الفئران فقط وهي تسمح بتخطي الحاجز الدموي الدماغي الذي يفصل بين الدم وسائل خارج الخلية الدماغية في الجهاز العصبي المركزي وهو ما كان يشكل عقبة في أبحاث الأدوية الخاصة بالأعصاب لان هذا الحاجز كان يغلق الباب في وجه جزيئات كبيرة مثل الأجسام المضادة ويمنعها من الوصول الى المخ.
ومرض الزهايمر هو مرض قاتل يقضي على وظائف المخ وأصاب 44 مليون شخص على مستوى العالم وتتوقع الجمعية الدولية لمكافحة الزهايمر أن عدد المصابين بالمرض سيزيد لثلاثة أمثاله بحلول عام 2050.
وعلى الرغم من انه لا يوجد حتى الآن علاج من المرض بشكل فعال أو دواء لإبطائه تجري عدد من الشركات منها روش وإيلي ليلي وميرك آند كو وجونسون آند جونسون أبحاثا للوصول إلى أصل المرض.
وثبت أن هذه المعركة ليست سهلة. فعلى مدى 15 عاما فشل أكثر من مئة دواء تجريبي للزايمر في مراحل الاختبار. لكن محللي الصناعة يعتقدون ان العائد سيكون مجزيا في حالة التوصل إلى علاج حقيقي للمرض وقدروا سوق المبيعات بنحو عشرة مليارات دولار في العام.
وتعمل التكنولوجيا المستحدثة لروش باختطاف آلية نقل طبيعية يستخدمها جسم الإنسان بشكل طبيعي لنقل البروتينات داخل المخ.
وقال لوكا سنتاريلي رئيس قسم علوم الأعصاب وأمراض العيون والإمراض النادرة في روش خلال اتصال هاتفي "صممنا في الأساس هذه المركبة التي أطلق عليها اسم المكوك التي تلتحم مع آلية النقل هذه وتنقل شحنة إلى المخ".
وخلصت نتائج الدراسة التي نشرت أمس الأربعاء في دورية "نيورون" إلى أن هذه لتكنولوجيا ساعدت على زيادة تركيز الأجسام المضادة في أدمغة فئران التجارب وأنها خفضت حجم الصفائح النشوية التي تعد علامة أكيدة على الإصابة بالزهايمر.
اقرأ أيضاً
أخبار ذات صلة
مساحة إعلانية
مساحة إعلانية
الأكثر مشاهدة

مع ارتفاع درجات الحرارة واقتراب موسم الإجازات الصيفية، يتجه المواطنون والمقيمون والزوار إلى استكشاف الوجهات البحرية والشواطئ والاستمتاع بالأنشطة الخارجية في قطر، خاصة...
21168
| 02 يونيو 2026

أغلقت وزارة البلدية 3 منشآت غذائية بينها هايبر ماركت شهير للمرة الثانية هذا العام لمخالفة قانون تنظيم الأغذية الآدمية رقم 8 لسنة 1990...
15970
| 04 يونيو 2026

سجلت دولة قطر، أعلى درجات حرارة، نهار اليوم الأربعاء، لتبلغ درجة الحرارة في منطقة مطار الدوحة الدولي 47 درجة مئوية، وهي نفس درجة...
13594
| 03 يونيو 2026
مساحة إعلانية
مساحة إعلانية
الشرق الإقتصادي

أعلنت اليابان اليوم انضمامها إلى مشروع الذكاء الاصطناعي الأمريكي مهمة جينيسيس (Genesis Mission) التابع لوزارة الطاقة الأمريكية، لتصبح أول شريك دولي في هذه...
72
| 05 يونيو 2026

وافق البرلمان الياباني، اليوم، على ميزانية تكميلية بقيمة 3.1 تريليون ين ياباني أو نحو 19 مليار دولار، في إطار سعي الحكومة لدعم الأسر...
64
| 05 يونيو 2026

قالت منظمة التجارة العالمية، اليوم، إن هناك مؤشرات على أن نمو تجارة السلع العالمية ربما بدأ في التباطؤ على الرغم من المرونة التي...
60
| 05 يونيو 2026

أعلن مكتب الإحصاء الأوروبي يوروستات أن اقتصاد منطقة اليورو سجل انكماشا طفيفا خلال الربع الأول من عام 2026، وذلك في إطار التقديرات النهائية...
80
| 05 يونيو 2026
مساحة إعلانية

حمل تطبيق الشرق
تابع الأخبار المحلية والعالمية من خلال تطبيقات الجوال المتاحة على متجر جوجل ومتجر آبل
آخر المقالات
-
حين يكون السكوت أبلغ من الكلام

د. فاطمة سعد النعيمي
-
ماذا يحدث عندما تشترى الشهرة؟

د. طالب العذبة
-
فيتامين د.. أكثر من مجرد فيتامين للعظام

د. مصطفى محمد عبيد
-
أهمية تنمية وإدارة الموارد البشرية

رحاب أحمد عثمان محمد
الأكثر رواجاً
- 1 الصحة تعلن سحب منتج شوكولاتة منشأ السعودية.. وتحذر ممن يعانون حساسية البيض من استهلاكه
أعلنت وزارة الصحة العامة عن سحب منتج شوكولاتة (GODIVA Kunafah & Pistachio Milk Chocolate Bar) منشأ المملكة العربية السعودية، وذلك لعدم ذكر البيض...
10220
| 03 يونيو 2026
- 2 بالتنسيق مع الداخلية.. وزارة المواصلات: تفتيش 66 سيارة ليموزين وضبط 3 مخالفات
نفذت وزارة المواصلات حملة تفتيشية مكثفة على سيارات الليموزين التابعة للشركات التي تمارس نشاط نقل الركاب عبر التطبيقات الإلكترونية، خلال أيام عيد الأضحى...
9824
| 04 يونيو 2026
- 3 التقديم 1 يوليو والراتب 8 آلاف ريال و40 ألف بدل ما قبل السفر.. تعرف على مزايا برنامج الابتعاث الأميري
يبدأالتقديم علىبرنامج الابتعاث الأميريضمن خطة الابتعاث الحكومي 2026–2027 من 1 يوليو إلى 15 أغسطس المقبلين، حيث يتيح البرنامج فرص الابتعاث للبكالوريوس والدراسات العليا...
9788
| 03 يونيو 2026








